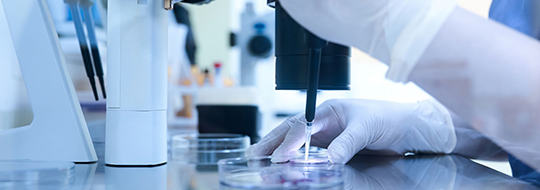

At Panacea Fertility Center, hope meets healing. Every challenge is met with expert care, and every dream of parenthood is embraced with dedication. Our compassionate team walks with you through the struggles of infertility, guiding you towards the joy of starting a family.
Since 2012, our mission has been simple yet powerful – to stand beside you through every high and low on your journey to parenthood.
Born from the vision of We Care Hospital Services, Panacea Fertility Center offers more than just advanced fertility treatments. We provide the emotional support, understanding, and reassurance you need at every step. From your very first consultation to the precious moment you hold your baby, we are committed to being your constant partner.
With centers in Nashik and Yeola, we blend world-class medical technology with a warm, personalized approach. Whether you’re beginning your fertility journey or continuing it, every treatment is tailored to your unique story.




At Panacea, our care extends far beyond medical treatments. We take the time to truly listen, understand your concerns, and help you overcome every hurdle on your fertility journey. From the very first step, we’re by your side—offering guidance, compassion, and everything needed to make your experience as smooth and stress-free as possible, so you can focus on what matters most: each other.


We believe science should simplify your journey through infertility, not complicate it. That’s why we empower every couple to play an active role, making informed decisions with clarity and confidence. Parenthood is a shared dream, and understanding your path is the first step to achieving it.
With the most advanced technologies and a deeply caring approach, we strive to create an experience that is both comfortable and reassuring. From the very first conversation, our promise of care begins—and it stays with you, every step of the way, until your dream becomes reality.

Consistently achieving positive outcomes with proven fertility treatments tailored to each couple.
Equipped with cutting-edge equipment to ensure accuracy, efficiency, and better results.
Offering the latest ART methods to maximize the chances of successful conception.
A state-of-the-art lab ensuring precision, safety, and international standards of care.
A team of skilled fertility experts with years of expertise in reproductive medicine.
Continuously innovating to provide advanced solutions for complex infertility cases.
A space where science meets creativity to push boundaries in fertility care.
Every treatment is uniquely designed around your individual medical and emotional needs.
From diagnostics to advanced fertility procedures, everything in a single center.
Open communication, honest guidance, and clarity at every step of your journey.
Strictly adhering to ethical practices to provide safe, responsible, and respectful treatments.
World-class fertility care designed to be within reach for every hopeful parent.
A nurturing, supportive atmosphere that prioritizes comfort, empathy, and well-being.